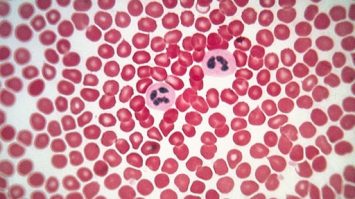

Comical Reactions with Mike & Billy
Experience Precision With Our Products








Mr. Pramod Gautam, QC Manager at ACC Cement (Katni M.P.) uses Scitus Bottle Top Dispenser in their laboratory for mortar preparation. It is a highly accurate lab equipment that operates on Springless Valve™ technology that facilitates smooth and safe dispensing of chemicals.
To know more about it, visit: https://www.microlit.com/product/microlit-scitus/


Inspired by the ‘Lego-like’ properties of DNA, with building blocks that are typically 20,000 times smaller than a human hair, a new DNA-based fluorescent nanoantenna will monitor the structural change of proteins over time.
Read More
Fortunately, there are a number of different techniques you can use to minimize or correct for these matrix effects, enabling accurate, reliable results and ensuring your method meets regulatory standards.
Read More
Blood smears, in which a drop of blood is spread into a thin layer on a microscope slide, are used to diagnose several blood-borne diseases such as malaria. The ability to make accurate diagnoses using this technique requires high-quality, consistent smears typically relying on the skill of the technician creating the smears by hand.
Read More

Bottle Top Dispensers are the go-to scientific apparatus for dispensing reagents safely and precisely in laboratory environment. They can safely dispense a fixed amount of liquid, usually between 1 ml and 100 ml, directly from a bottle to a receiving container. The components of a bottle top dispenser include piston, glass barrel, volume adjustment knob, dispensing nozzle, nozzle cap, inlet tube and bottle adaptors.
Read our Blog

On a scale of 1 to 5, how much did you like this edition? Share your rating & email id and receive a free calibration check tool in your inbox!